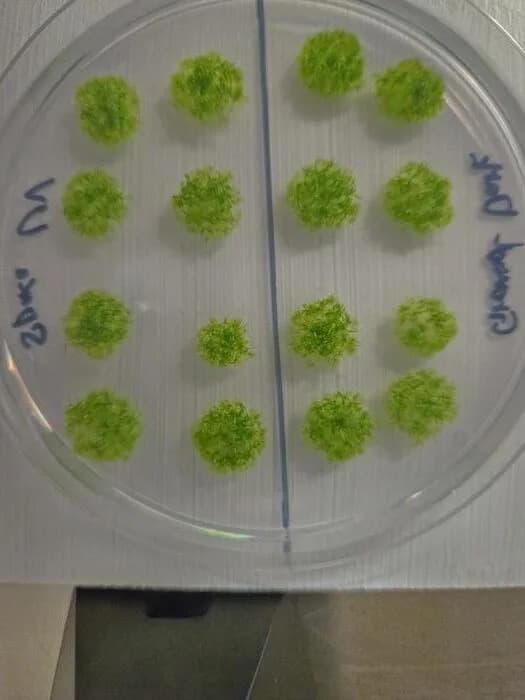
Mahovina preživela 283 dana u svemiru — izdržljivost koja iznenađuje

Ključni rezultati: Sporofiti mahovine Phycomitrium patens preživeli su 283 dana na spoljašnjoj strani ISS-a — više od 80% uzoraka je preživelo, a 89% od njih je moglo da klija po povratku. Najveći štetni faktor bio je UV zračenje, koje spore delimično neutralizuju zaštitnom kapsulom. Modeli sugerišu da bi spore u idealnim uslovima mogle preživeti i do 15 godina u svemiru.
Mahovina preživela 283 dana u svemiru — izdržljivost koja iznenađuje

Mahovine su među najotpornijim biljkama na Zemlji: pionirske vrste koje uspevaju u ekstremnim uslovima — od Dolina smrti do Antarktika. Novo istraživanje pokazuje da je jedna takva vrsta, Phycomitrium patens, uspela da preživi boravak na spoljašnjoj strani Međunarodne svemirske stanice (ISS) tokom 283 dana.
Izbor vrste i laboratorijski testovi
Vođa studije Tomomichi Fujita i tim izabrali su Phycomitrium patens (spreading earthmoss) jer je dobro proučena i široko rasprostranjena. Pre nego što su poslali uzorke u svemir, istraživači su u laboratoriji testirali tri razvojne strukture mahovine: mladu mahovinu, brood ćelije (specijalizovane matične ćelije koje nastaju pod stresom) i sporofite (reproduktivne strukture koje stvaraju spore). Najveći štetni faktor bio je UV zračenje, pri čemu su sporofiti pokazali znatno veću otpornost nego mlade forme i brood ćelije.
Misiја na ISS i rezultati
Godine 2022. stotine sporofita su poslati na ISS i privremeno postavljeni na spoljašnjoj strani stanice na 283 dana. Nakon povratka na Zemlju, rezultati su nadmašili očekivanja istraživača.
„Očekivali smo skoro nikakav opstanak, ali rezultat je bio suprotan. Većina spora je preživela — bili smo zapanjeni izuzetnom izdržljivošću ovih sićušnih biljnih ćelija.“ — Tomomichi Fujita
Više od 80% sporofita preživelo je put do i iz svemira, a 89% od preživelih moglo je da klija po povratku. Ključni faktor uspeha delimično je zaštitna kapsula svake spore koja deluje kao hemijska i fizička barijera i apsorbuje štetno UV zračenje. Većina tipova hlorofila ostala je na uobičajenom nivou; jedino je hlorofil a smanjen za oko 20%, što nije imalo vidljiv negativan uticaj na sposobnost klijanja.
Značaj i moguća primena
Na osnovu laboratorijskih podataka i modela, istraživači procenjuju da spore ove vrste, u idealnim uslovima, teoretski mogu preživeti i do 15 godina u svemiru. Otkriće naglašava izuzetnu otpornost jednostavnih oblika života i otvara pitanja o mogućim implikacijama za razumevanje prenosa života između nebeskih tela (panspermija), kao i za razvoj biotehnoloških rešenja i zaštite biljaka u budućim svemirskim misijama.
Ipak, autori ističu da su potrebna dodatna istraživanja kako bi se razjasnili dugoročni efekti kosmičkog zračenja, ekstremnih temperatura i mikrograwitacije na različite faze životnog ciklusa mahovina i mogućnosti njihove upotrebe u svemirskim uslovima.
„Ova studija pokazuje zapanjujuću otpornost života koji je nastao na Zemlji,“ zaključio je Fujita.
Pomozite nam da budemo bolji.